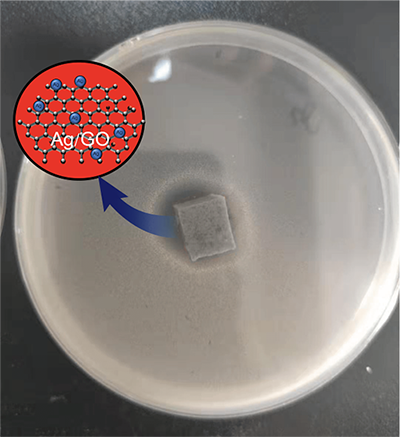

Antibiotic Silver Particles Coated Graphene Oxide/polyurethane Nano-composites Foams and Its Mechanical Properties
YANG Zhi, LI Kun-Rong, ZHANG Yuan-Ye, HU Jia-Le, LI Tian-Yuan, WENG Zi-Xiang* and WU Li-Xin*
Chin. J. Struct. Chem. 2022, 41, 2203125-2203131 DOI: 10.14102/j.cnki.0254-5861.2011-3273
March 15, 2022
graphene, nanocomposite, polyurethane foams, antibacterials
ABSTRACT
Silver nanoparticles (AgNPs) are widely
adopted in polyurethane foams (PUFs) as a type of antibacterial agent. However,
due to its poor interfacial interaction, AgNPs are difficult to be dispersed in
the polymer matrix uniformly, which deteriorates the enhancement
effect. In this paper, silver-coated graphene
nanocomposite (Ag/GO) is prepared by an enzyme reductant which is efficient and
non-toxic. Compared with traditional antibacterial agent, the Ag/GO
nanoparticles can be uniformly dispersed in the nanocomposite, which means that
Ag/GO can be well- dispersed into the polyurethane foams (PUFs). Compared with
AgNPs modified PUFs, the as-prepared Ag/GO modified PUFs
have a 1.85% improvement in resilience, 7.9% improvement in tensile strength,
6.52% improvement in tensile elongation, and 8.74% improvement in bacteriostats
rate at a loading of 0.4%.